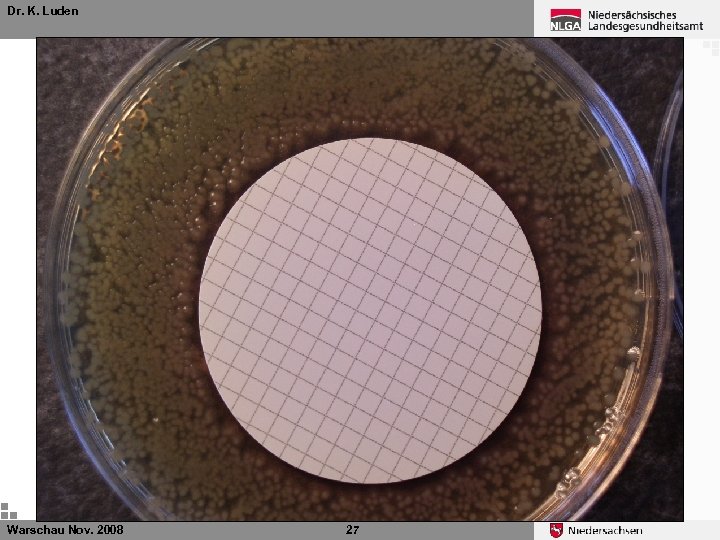
Dr. K. Luden Ø Warschau Nov. 2008 27

96c61aaae703903c19f068167f4f829f.ppt
- Количество слайдов: 34

Dr. K. Luden Lab Quality Assurance by Interlaboratory Comparisons Proficiency Testing Warschau Nov. 2008 1

Dr. K. Luden Drinking water directive 98/83/EC Annex III Specifications for the analysis of Parameters Each Member State must ensure that any laboratory at which samples are analysed has a system of analytical quality control that is subject from time to checking by a person who is not under the control of the laboratory and who is approved by the competent authority for that purpose. Warschau Nov. 2008 2

Dr. K. Luden German drinking water directive § 15 Methods of Analysis and Laboratories (4) The nessessary analysis including sampling are to be conducted by laboratories that work by “generally accepted rules of the technology” (allgemein anerkannte Regeln der Technik), have a system of internal quality control, participate at least once a year in external quality assurance schemes, have sufficiently qualified personell and are accredited by a generally recognized accreditation body. The responsible highest federal authority will publish a list of laboratories in its jurisdiction. (5) The authorities (of the federal state) independent of the labs will have to check regularly wether the conditions of (4) are still fullfilled. Warschau Nov. 2008 3

Dr. K. Luden Proficiency testing Participation in proficiency testing programs allows laboratories to: Ø identify areas where improvement in their testing and measurement methods is needed Ø identify further training of their staff Ø foster confidence in the performance of their testing and measurements Ø assure laboratory performance in their accredited test and calibration results Warschau Nov. 2008 4

Dr. K. Luden Jungle of standards for PT / EQA There are several standards and guidelines for providing PT / EQA schemes (in chronological order) • ISO/IEC Guide 43 -1: 1996 Proficiency testing by Interlaboratory Comparisons – Part 1: Development and Operation of Proficiency testing Schemes • ISO 13528: 2005 Statistical Methods for use in Proficiency Testing by Interlaboratory comparisons • IUPAC Technical Report 1/2006 The International Harmonized Protocol for the Proficiency Testing of Analytical Chemistry Laboratories • ILAC-G 13: 2007 ILAC Guidelines for the Competence of Providers of Proficiency Testing Schemes • ISO/TS 20612 Water Quality – Interlaboratory comparisons for proficiency testing of analytical chemistry laboratories • ISO/IEC CD 17043: 2008 Conformity Assessment – General Requirements for Proficiency Testing Warschau Nov. 2008 5

Dr. K. Luden External Quality Assurance Recommendation of Federal Environmental Agency 2002 - Microbiology Warschau Nov. 2008 6

Dr. K. Luden External Quality Assurance Recommendation of Federal Environmental Agency 2002 - Microbiology successfull participation in proficiency testing schemes Parameter E. coli/Coliform bacteria Enterococci Colony Count 2 x / year Clostridium perfringens Legionella Pseudomonas aeruginosa 1 x / year Enteropathogenic Viruses Cryptosporidium parvum International PTS Warschau Nov. 2008 7

Dr. K. Luden External Quality Assurance Recommendation of Federal Environmental Agency 2003 - Chemistry successfull participation in proficiency testing schemes Parameter All parameters offered by a laboratory 1 x within 2 -3 years Ø Proficiency testing (PT) according to DIN 38402 -45 Warschau Nov. 2008 8

Dr. K. Luden German drinking water PT providers Ø Microbiology and “hygenic-chemical PT Ø Chemistry PT Regular meetings, harmonized schedules, identical statistical evaluation → comparability for labs and authorities Warschau Nov. 2008 9

Dr. K. Luden DIN 38402 -45 Ø Standard may be applied if: Ø Parameter analysed can be considered continuously measureable true for most chemical and phisico-chemical parameters not allways true for biological and/or microbiological parameters Ø Application in Chemistry: Yes Ø Application in microbiology: by way of trial / mostly Warschau Nov. 2008 10

Dr. K. Luden Microbiology PT The governmental Institute of Public Health of Lower Saxony (NLGA) is Proficency Test (PT) provider for microbiological measurements in drinking water in Germany Every year: Ø 4 PTS for E. coli/coliform bacteria, Enterococci, and Colony Counts Ø 2 PTS for Pseudomonas aeruginosa, Clostridium perfringens and Legionella Ø 1 PTS for EU bathing water (E. coli, coliforme B. ) Ø 1 PTS for selected “hygenic-chemical” parameters Warschau Nov. 2008 11

Dr. K. Luden Microbiology PT Parameter E. coli-coliform bacteria Colony Count Enterococci Clostridium perfringens Pseudomonas aeruginosa Qualified methods 1986 1999 presence/absence test + DIN EN ISO 9308 -1 (+) Colilert®-18/Quanti-Tray® German DWD 1990 + DIN EN ISO 6222 EN ISO 7899 -2 Chromocult®-Enterococci-Agar DWD (m. CP-Agar) TSC 2000 2001 2002 2003 2004 2006 2007 2008 + (+) + + + + (+) + + + (+) (+) + + + + (+) DIN EN ISO 9803 -3 (+) + + DIN EN ISO 7899 -2 DIN EN ISO 7899 -1 (+) + + EN 12780/ISO 16266 (+) + + + + + Legionella spec. GVPC (ISO 11731 -2) EC bathing water directive Feacal coliform bacteria E. coli-coliform bacteria Intestinal Enterococci Warschau Nov. 2008 + 12 +

Dr. K. Luden Microbiology PT Parameter E. coli-coliform bacteria Colony Count Enterococci Clostridium perfringens Pseudomonas aeruginosa Qualified methods 1986 1999 presence/absence test + DIN EN ISO 9308 -1 (+) Colilert®-18/Quanti-Tray® German DWD 1990 + DIN EN ISO 6222 EN ISO 7899 -2 Chromocult®-Enterococci-Agar DWD (m. CP-Agar) TSC 2000 2001 2002 2003 2004 2006 2007 2008 + (+) + + + + (+) + + + (+) (+) + + + + (+) DIN EN ISO 9803 -3 (+) + + DIN EN ISO 7899 -2 DIN EN ISO 7899 -1 (+) + + EN 12780/ISO 16266 (+) + + + + + Legionella spec. GVPC (ISO 11731 -2) EC bathing water directive Feacal coliform bacteria E. coli-coliform bacteria Intestinal Enterococci Warschau Nov. 2008 + 13 +

Dr. K. Luden PT samples - two options Liquid samples Freeze dried material Bacterial solution in defined mineral medium Bacteria adsorbed to milk powder Very realistic samples Handling exactly like a real sample A solution has to be prepared and first step of handling procedure is different from real samples Stability 4 -6 days after shipment at <10°C Stability at -20°C weeks or months Germany United Kingdom, France, Sweden, Australia. . . Warschau Nov. 2008 14

Dr. K. Luden Preparation at NLGA Warschau Nov. 2008 15

Dr. K. Luden Shipping 300 - 500 participants/PT Registered: > 700 Labs from Germany Austria (26) Switzerland (8) Lithuania (2) Hungary (2) Great Britain (1) Luxembourg (1) Warschau Nov. 2008 16

Dr. K. Luden Schedule of a proficiency testing scheme Ø Registration of participants Ø Confirmation of the registration (4 weeks before PT) Ø Preparation of the samples and shipment Ø Internal quality control (two weeks before and 6 days after shipment) Ø Reporting of the results (within 16 days of shipment) Ø Evaluation of the results usually within 4 weeks after the deadline for reporting Warschau Nov. 2008 17

Dr. K. Luden What do the labs get? Ø Report on the PT design, special problems, interesting results etc. Ø Certificate and evaluation report (target value as consensus value of participants results) Ø Quality control charts about the influence of temperature and the duration of shipping Ø Z(u)-Scores of all measurements in tables Ø Z(u)-Scores in graphic form Warschau Nov. 2008 18

Dr. K. Luden Statistics of DIN 38402 -45 Ø Robust statistics (no outlier tests); consensus mean (used as assigned value) calculated by Hampel Estimator m-4, 5 s m-3 s m-1, 5 s m m+1, 5 s m+3 s m+4, 5 s Ø ZU-scores “normalize” the results for comparing different levels of bacterial concentration l. ZUl 2 - sufficient l. ZUl 3 - questionable l. ZUl > 3 - insufficient Z-score: Warschau Nov. 2008 19

Dr. K. Luden Certificate Name/Adress of PT-provider Address of participant Identification of PT (e. g. 3 -2008) Table of parameters, successfully analyzed param. And method used Signatures of PT provider Warschau Nov. 2008 20

Dr. K. Luden Microbiology PT ZU-score Group B III-2008 E. coli (assigned value 21 CFU/100 ml) Labcode Warschau Nov. 2008 21

Dr. K. Luden Interlaboratory comparisons Ø method validation studies: aptitude/qualification of the lab is prerequisite reference material is fit for purpose Ø to certify reference material: method is supposed to be fit for purpose/valid labs are expert labs Ø Quality control/proficiency testing: performance of a lab is tested, reference material and method are supposed to be valid/fit for purpose Warschau Nov. 2008 22

Dr. K. Luden E. coli PT 1 -2003 45 40 E. coli CFU / 100 ml 35 30 25 20 15 10 5 X+3 s 36 X+2 s 386 X 60 23 X-2 s 391 Warschau Nov. 2008 X-3 s 522 E. coli / 100 ml 545 Labcode 149 279 116 460 367 284 469 442 328 219 459 437 340 56 178 543 445 406 162 12 35 183 3 428 5 R R R R R 0

Dr. K. Luden Clostridium perfringens CFU/100 ml PT 2 -2004 Labcode Warschau Nov. 2008 24

Dr. K. Luden Clostridium perfringens Medium/method used Recovery rate Columbia blood agar / membrane filtration 100 % Columbia blood agar / membrane filtration no shaking of the sample 39 % DEV-Nutrient agar / pour plate method 78 % m. CP Agar / Filtration (24 hours TNT) 43 % m. CP Agar / Filtration (24 hours 4°C) 43 % m. CP Agar / Filtration (PT participants mean) 11 % Warschau Nov. 2008 25

Dr. K. Luden Clostridium perfringens Medium/method used Recovery rate Columbia blood agar / membrane filtration 100 % Columbia blood agar / membrane filtration no shaking of the sample 39 % DEV-Nutrient agar / pour plate method 78 % m. CP Agar / Filtration (24 hours TNT) 43 % m. CP Agar / Filtration (24 hours 4°C) 43 % m. CP Agar / Filtration (PT participants mean) 11 % Warschau Nov. 2008 26
Dr. K. Luden Ø Warschau Nov. 2008 27

Dr. K. Luden Pseudomonas aeruginosa In PT 1 -2007 30 % of labs failed because they reported a numerical result for P. aeruginosa when the strain provided was not a P. aeruginosa Possible explanation: Warschau Nov. 2008 a id ut P. p os in ug P. a er e iv at eg 28 a tr. co n es ci pe N P. s E. c ol i problems with confirmation reaction - Ammonia formation from acetamide

Dr. K. Luden E. coli A pure culture of E. coli was used in PT 4 -2004 ISO 9308 -1: 2, 4 % Colilert®-18: 18, 8 % ISO 9308 -1 (n = 246) 61 0 30 15 21 24 Warschau Nov. 2008 Coliform bacteria 68 25 54 16 22 25 delta 7 25 24 1 1 1 29 E. coli Coliform bacteria delta 0 66 62 74 0 0 74 30 48 48 50 53 19 24 27 False results: E. coli Colilert (n = 80) 66 70 70 78 78 83 83 43 50 53 53 59 21 25 45 66 4 8 4 78 83 9 13 2 5 3 6 2 1 18

Dr. K. Luden Explanation? ß-Galactosidase ß-Glucuronidase Warschau Nov. 2008 30

Dr. K. Luden Conclusions Ø Interaction between filter and nutrient agar might be unfavorable for growth of the target organism Ø Performance of the material combinations used has to be checked (even if supplied with a certificate) Ø Negative controls are as important as positive controls Ø One can learn about the methods while testing performance of the lab Ø. . Warschau Nov. 2008 31

Dr. K. Luden Thank you for your attention! Warschau Nov. 2008 32

Dr. K. Luden Most likely errors - E. coli / coliforms Ø Formal mistakes in the results: E. coli is part of the group of coliforms, therefore the number of E. coli cannot be larger than the number of total coliforms Ø Commercial identification systems (that are not to be used for the PT) might give conflicting results with the PT method Ø ISO 9803 -1: 44°C Indole formation, wrong or not exactly controlled incubation temperature (use a waterbath) Ø Colilert®-18: measurements carried out at the wrong wavelength; cavities not properly filled. Warschau Nov. 2008 33

Dr. K. Luden Most likely errors colony counts Ø Contamination of the molten agar or the sample Ø Temperature of the agar too high: a slight increase in temperature might cause considerable decrease in numbers of bacteria that are able to form colonies; too low temperatures might lead to uneven distribution of bacteria as the agar starts clumping and proper mixing is prevented Ø Volume of agar is too small Warschau Nov. 2008 34
96c61aaae703903c19f068167f4f829f.ppt